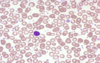

Week 1- Myeloproliferative disorders Flashcards
What are myeloproliferative disorders?
Myelo= myeloid lineage (red cells, platelets, granulocytes) Proliferative= to grow or multiply They are clonal haematopoetic stem cell disorders with an increased production of one or more types of haemopoetic cell. Basically proliferation of mature cells.
How do myeloproliferative disorders differ from acute leukaemia?
Maturation is preserved.
Which gene is responsible for the division of myeloproliderative disorders?
Presence or absence of BCRABL1 gene. If you have it- chronic myeloid leukaemia If you dont- one of the other three.
What makes up the BCRABL1 negative myeloproliferative disorders?
Polycythaemia (rubra) vera Myelofibrosis Essential thrombocytosis.
Where is BCRABL1 gene found?
On the Philadelphia chromosome.
What does chronic myeloid leukaemia cause in terms of cells?
Overproduction of granulocytes.
What does essential thrombocytosis cause in terms of cells?
Overproduction of platelets.
What does polycythaemia rubra vera cause in terms of cells?
Overproduction of red cells.
When would you suspect myeloproliferative disorders?
When there is: High granulocyte count +/- High red cell count +/- High platelet count +/- Eosinophillia/basophillia Splenomegaly thrombosis in an unusual place.
Which myeloproliferative disorder is splenomegaly most commonly associated with?
Myelofibrosis. However can be seen in the others.
In chronic myeloid leukaemia, what is blast crisis?
When you get proliferation of blast cells (so it appears like acute myeloid leukaemia) however it is a very late stage of chronic myeloid leukaemia.
What are the clinical features of chronic myeloid leukaemia?
Splenomegaly Hypermetabolic syndromes- increased rate. Gout Problems in the blood due to increased viscosity.
What laboratory features are there of chronic myeloid leukaemia? Think about blood counts etc.
Chronic myeloid leukaemia- lots of mature cells proliferating. Therefore normal Hb/decreased Hb. Leucocytosis, neutrophillia and myeloid precursors, eosinophilia, basophilia (not many conditions cause a rise in basophils however CML does).
Which type of cell are the arrows pointing too in this picture? Also which myeloproliferative disorder does this indicate?

Eosinophils are shown- they have red granules in their cytoplasm.
Likely to be chronic myeloid leukaemia as there is basophillia and eosinophillia which are unlikley to be seen outwith this disease.
Which chromosomal abnormalitity is said to be the hallmark of chronic myeloid leukaemia? What changes to this chromosone produce which specific gene that causes CML?
The phillidelphia chromosone.
Translocation between chromosone 9 and 22. Causes BCR and ALB genes to stick together- causing BCR ABL causative gene.
What is the product of having the BCR-ABL gene?
What does this mean for treatment?
Causes a tyrosine kinase which causes abnormal phosphorylation (signalling) in the myeloid pathway leading to the haematological changes in CML.
Durable diseases may respond to tyrosine kinase inhibitors.
NOTE- the BCR ABL negative diseases may overlap so there may be difficulty distinguishing between them.
Name some common features of myeloproliferative disorders?
Asymptomatic- commonly picked up by chance due to people having blood tests done.
Increased cell turnover-e.g. gout, fatigue, weight loss, sweats.
Symptoms or signs due to splenomegaly
Why do you get a low haemoglobin in chronic myeloid leukaemia?
It stops the ability of the bone marrow to make normal healthy blood cells, meaning that anaemia will occur.
Describe this blood test:
What are you worried about?

This person has a low Hb- normocytic anaemia (due to MCV being normal)
High platelets- thrombocytosis
High WBC- leucocytosis- specifically neutrophils, eosinophils and basophils (neutrophillia, eosinophillia and basophillia)
In this patient you are worried about chronic myeloid leukaemia.
Describe this blood test?
Are you worried about chronic myeloid leukaemia in this case?

Hb is low- normocytic anaemia (as MCV is normal)
Raised WBC count- leucocytosis
Raised platelets- thrombocytosis
This person has a neutrophillia but the basophils and eosinophils are within the normal range
You are not worried because the clinical history suggests infection (empyema) which would also cause these blood results. Cancer investigation is only warranted if the clinical picture also fits.
What drug can be used for chronic myeloid leukaemia? Explain why?
Tyrosine kinase inhibitors e.g. imatinib
(tyrosine kinase causes abnormal phosphorylation leading to the haematological changes)
Describe the bloods in polycythaemia rubra vera?
High haemoglobin/haematocrit with erythrocytosis (a true increase in red cell mass). There can be excessive production of other lineages.
What is polycythaemia rubra vera important to distinguish from?
Secondary polycythaemia- chronic hypoxia (e.g. in COPD patients), erythropoetin secreting tumours)
Pseudopolycythaemia-e.g. dehydration, diuretic therapy. Concentrates the blood making the red cell mass SEEM more than normal. You will see an increase in haematocrit.
What is haematocrit?
Percentage of blood volume composed by red cells.
These images illustrate true vs pseudo polycythaemia.

In pseudopolycythaemia- the RBC level is normal but the plasma volume has decreased therefore making the red cell mass appear to be higher.

What clinical features can you get with polycythaemia rubra vera?
All the clinical features common to myeloproliferative disorders e.g. splenomegaly, asymptomatic, gout, fatigue, weight loss, sweats.
BUT ALSO
Headache, fatigue
Itch- called aquagenic priuritis- itch that occurs in exposure to warm water.
How do you investigate polycythaemia rubra vera?
History- look for any suggestions of secondary polycythaemia e.g. chronic COPD
Examine- for splenomegaly
FBC and film
JAK2 mutation status
What is the significance of the JAK2 mutation status?
When would you test for JAK2 mutations?
JAK2 is a kinase.
Mutations in this present in over 95% of patients.
The mutation results in auto-inhibiton meaning uncontrolled erythropoeisis occurs.
JAK2 mutation testing is part of the initial screening for polycythaemia rubra vera.
What other investigations may be relevant in polycythaemia?
Possible CXR- to look for underlying secondary cause.
Infrequently- erythropoetin and bone marrow biopsies are done.
What is the main aim of treatment of polycythaemia?
What additional treatment is given and for what reason?
Reduce the haematocrit to below 0.45. This is done by venesection.
Aspirin is given because of risk of thrombotic event.
If intolerant of all other therapies you can give cytotoxic oral chemotherapy e.g. hydroxycarbamide.
What is essential thrombocythaemia characterised by?
A primary condition of having high platelets.
On the blood film you can see lots of platelets. Also some platelets are large and show reactive changes.
Is platelet function normal or abnormal in essential thrombocythaemia?
Platelets are high however ABNORMAL. Patients may have thrombosis.
Patients can also be at risk of bleeding due to acquired VWF disease.
Why can you have acquired VWF disease?
The level of platelets is so high that the VWF is insufficient for platelet adhesion.
What clinical features can be seen in essential thrombocythaemia?
Bleeding-unpredictable risk esp in surgery
Features common to myeloproliferative disorderse e.g. night sweats, fatigue
Describe the following blood test results.

Really high platelet levels- thrombocytosis
Everything else is within the normal range.
The clinical picture of painful discoloured toe suggests spontaneous bleeding in the toe, fitting with the suspicion of essential thrombocythaemia.
Describe the following blood results.
Haemoglobin low- normocytic anaemic (due to MCV being normal).
Platelets are v high- therefore thrombocytosis.
Neutrophil count is raised- neutrophillia.
Clinical picture shows an AAA repair. This is likely to be the cause of the patients anaemia. It is also likely that the increased EPO has also caused the high platelet count.

How would you diagnose essential thrombocythaemia?
Exclude reactive thrombocytosis e.g. blood loss, inflammation, malignancy, iron deficiency
Exclude CML
Look for JAK2 (present in 50% of cases) and in those who do not have this look for CALR. If CALR negative look for MPL
Characteristic bone marrow appearence.
If the genetic tests are all negative, does this rule out essential thrombocythaemia?
No- 15% of cases wont have a genetic cause.
What will the bone marrow appearence of someone with essential thrombocythaemia look like?
Lots of megakaryocytes (platelet precursors).
Clusters of these will be seen in the bone marrow.
When would you carry out marrow testing in suspected essential thrombocythaemia?
If there is no obvious cause look at the marrow.
How do you treat essential thrombocythaemia?
Anti-platelet agents e.g. aspirin
Cytoreductive therapy to control the proliferation e.g. hydroxycarbamine, anagrelide, interferon alpha.
When can myelofibrosis occur?
Idiopathic
Or
Post-polycythaemia or essential thrombocythaemia
What is idiopathic myelofibrosis?
Marrow failure (variable degrees)
Bone marrow fibrosis (no secondary fibrosis)
Extramedullary haematopoeisis (liver and spleen)
Leukoerythroblastic film appearences
Tear drop shaped RBCs in peripheral blood.
What are the clinical features of myelofibrosis?
Marrow failure- anaemia, bleeding, infection
Splenomegaly- LUQ pain, complications inc portal hypertension
Hypercatabolism- severe fever, cachexia (weight loss- as the spleen gets bigger it pushes on the stomach leading to lack of apetite and weight loss), sweats
What findings will be found in the lab in myelofibrosis?
Tear drop shaped RBC on blood film with leucoerythroblastic (anaemia resulting from SOL)
Dry bone marrow aspirate- as their bone marrow has no cells- will see fibrosis and trephine on biopsy
Some patients will have JAK2 or CALR mutations.

NOTES on leucoerythroblastic films-
What are the causes of leucoerythroblastic films?
Reactive (e.g. sepsis), marrow infiltration (e.g. lymphoma), myelofibrosis.
What will be seen on blood film of a leucoerythroblastic film?
Will see immature red blood cells (nucleated erythroblasts) and myelocytes (immature cells of myeloid lineage).

If a patient has tear drop RBCs on film and erthroblasts and myelocytes, what is this likely to be?
Points a strong finger towards myelofibrosis.
Describe the bone marrow biopsy of myelofibrosis?
A picture of how the marrow films differ is seen below- the bone marrow is meant to have a lot of spaces, however these are filled with fibrosis. Also loss of fat cells.

How do you treat myelofibrosis?
In a younger patient- allogenic stem cell transplantation
Supportive care e.g. blood transfusions, platelets and antibiotics.
JAK2 inhibitors can be used as effective treatment however the mutation is only present in about 50%. YOU DONT NEED THE MUTATION TO USE THIS DRUG. Can improve spleen size, qol. Example is Rutoxlitinib.